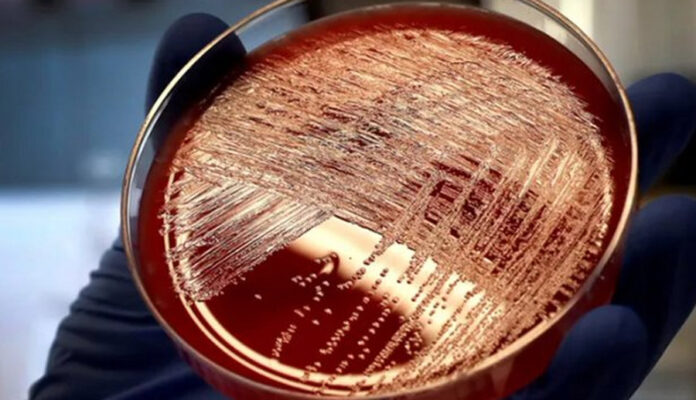
OMS riesgo de enfermedad invasiva por estreptococo A para población es

La enfermedad estreptocócica invasiva del grupo A (o enfermedad invasiva por estreptococo del grupo A) es definida como una infección asociada al aislamiento de Estreptococo del grupo A de un sitio estéril.
Los síndromes clínicos son tres:
- Síndrome del choque tóxico estreptocócico (SSTE), caracterizado por hipotensión (presión sistólica < == 90 mmHg en adultos o <5º percentil por edad en niños) y al menos dos de los siguientes signos.
- Necrosis de tejidos blandos incluyendo fascitis necrotizante, miositis o gangrena.
- Meningitis, bacteriemia sin foco identificado, neumonía, peritonitis, sepsis puerperal, osteomielitis, artritis séptica, infecciones de heridas postquirúrgicas.
Agente causal
Streptococcus pyogenes o Streptococcus β-hemolítico del grupo A (SGA) es una bacteria grampositiva implicada en una variedad de procesos infecciosos que van desde faringitis e impétigo hasta infecciones invasoras y graves como la fascitis necrotizante o el shock séptico. Además, S. pyogenes es capaz de causar síndromes postinfecciosos como la fiebre reumática y la glomerulonefritis.
Streptococcus pyogenes se clasifica serológicamente de acuerdo a los esquemas descritos por Griffith y Lancefield, basados en la identificación de los antígenos de las proteínas de la pared celular T y M. La proteína M es el mayor factor de virulencia de S. pyogenes y el gen que la codifica es el emm. Hay más de 120 proteínas M y tipos de secuencias emm diferentes. Los tipos M/emm 1 y M/emm 3 se asocian particularmente con las infecciones invasivas.
Reservorio
El reservorio es el hombre. Un 5-30% de la población es portadora asintomática faríngea de SGA.
Período de incubación
El periodo de incubación para la infección no invasiva por SGA varía de acuerdo al síndrome clínico entre 1 a 3 días, pero para la enfermedad invasiva por SGA (SGAi) no está determinado.
Mecanismo de transmisión
El SGA se disemina primariamente por gotitas, contacto de las membranas mucosas oral o nasal con secreciones respiratorias infecciosas o con exudados de heridas o lesiones cutáneas, o por contacto directo o indirecto de piel no intacta con exudados de piel o heridas o secreciones respiratorias. La infección es transmisible hasta 24 horas después de haber completado el tratamiento antibiótico.
Susceptibilidad
Aunque la SGAi puede afectar a individuos de cualquier edad y aparentemente sanos, los factores que con más frecuencia se han asociado al desarrollo de la infección han sido la edad mayor de 65 años, la infección por el virus varicela-zóster, la infección por VIH, la diabetes, la enfermedad cardíaca, la enfermedad pulmonar crónica, el cáncer, el tratamiento con altas dosis de esteroides, el alcoholismo y el uso de drogas por vía parenteral.
Epidemiología
La aparición de una agregación de casos de fascitis necrotizante en el Reino Unido, en 1994, fue seguida de un período de vigilancia de la enfermedad en muchos países europeos. En nuestro país, durante el período comprendido entre el año 1990 y septiembre de 1995, se estudió de forma retrospectiva y prospectiva la incidencia de la enfermedad, detectándose un total de 25 casos de fascitis necrotizante (2 en 1993, 17 en 1994, y 4 en 1995), debidos principalmente a infecciones por cepas del tipo M1. Posteriormente, a través del Sistema de Información Microbiológica (SIM), durante el período 1995-2006, se ha observado una estabilización en el número de casos declarados de SGAi, con una media de 30 casos anuales.
Clínica
Síntomas y señales tempranas de la Fascitis Necrotizante
- Fiebre
- Dolor fuerte e hinchazón
- Rojez en la zona de la lesión
Síntomas y señales tempranas del Síndrome de Shock Tóxixo Estreptocócico SSTE
- Fiebre
- Mareo
- Confusión
- Sarpullido rojo y plano en zonas grandes del cuerpo
Tratamiento
La enfermedad estreoptocócica invasiva por estreptococo grupo A se puede tratar con diferentes antibióticos. El tratamiento temprano puede reducir el riesgo de la muerte.
Quimioprofilaxis
Está indicada la quimioprofilaxis:
- A los contactos estrechos si tienen síntomas sugestivos de infección localizada (ej. faringe, fiebre, infección cutánea).
- A todos los convivientes si hay 2 o más casos de enfermedad invsiva por estreptococo grupo A en un periodo de 30 días.
- Madre o niño, si uno de ambos desarrolla enfermedad invsiva por estreptococo grupo A en el periodo neonatal (28 primeros días de vida).
La quimioprofilaxis debe administrarse lo antes posible, y preferiblemente antes de 24 horas después de la identificación del caso, pero es todavía recomendable hasta 7 días después del contacto con el caso infeccioso.
Pauta: